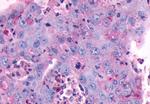
MC4R Antibody in Immunohistochemistry (Paraffin) (IHC (P))
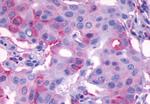
MC4R Antibody in Immunohistochemistry (Paraffin) (IHC (P))

Search
Invitrogen
MC4R Polyclonal Antibody
{{$productOrderCtrl.translations['antibody.pdp.commerceCard.promotion.promotions']}}
{{$productOrderCtrl.translations['antibody.pdp.commerceCard.promotion.viewpromo']}}
{{$productOrderCtrl.translations['antibody.pdp.commerceCard.promotion.promocode']}}: {{promo.promoCode}} {{promo.promoTitle}} {{promo.promoDescription}}. {{$productOrderCtrl.translations['antibody.pdp.commerceCard.promotion.learnmore']}}
产品信息
PA5-33925
种属反应
宿主/亚型
分类
类型
抗原
偶联物
形式
浓度
规格
纯化类型
保存液
内含物
保存条件
运输条件
RRID
产品详细信息
Percent identity with other species by BLAST analysis: Human, Chimpanzee, Gorilla, Orangutan, Gibbon, Baboon, Monkey, Marmoset, Tamarin, Horse (100%).
靶标信息
Expression of MC4R has been reported in brain. Unlike the other melanocortin receptors, MC4R is not expressed in adrenal cortex or in melanocytes. G-protein Coupled Receptors (GPCRs) comprise one of the largest families of signaling molecules with more than a thousand members currently predicted to exist. All GPCRs share a structural motif consisting of seven membrane-spanning helices, and exist in both active and inactive forms. An array of activating ligands participate in the conformation of GPCRs which leads to signaling via G-proteins and downstream effectors. Ongoing studies have also shown the vast series of reactions which participate in the negative regulation of GPCRs. This "turn-off" activity has tremendous implications for the physiological action of the cell, and continues to drive pharmacological research for new drug candidates. Two blockbuster drugs which have been developed as GPCR-targeted pharmaceuticals are Zyprexa (Eli Lilly) and Claritin (Schering-Plough) which have multi-billion dollar shares of the mental health and allergy markets, respectively.
仅用于科研。不用于诊断过程。未经明确授权不得转售。
篇参考文献 (0)
生物信息学
蛋白别名: MC4; MC4 receptor; MC4-R; Melanocortin receptor 4; mutant melanocortin-4 receptor; unnamed protein product
基因别名: BMIQ20; MC4R
UniProt ID: (Human) P32245
Entrez Gene ID: (Horse) 100050469, (Human) 4160